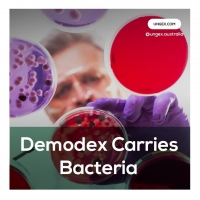
Demodex Carries Bacteria

Quickly to australia 1,4-Butanediol cas 110-63-4 BDO
Available From 2021-12-03 17:40:50 at Camberwell, Camberwell, Australia
Type: Offering
Category: Beauty & Salon Services, Services
Location: Camberwell, Camberwell, Australia
Quickly to australia 1,4-Butanediol cas 110-63-4 BDO
Buy online safety and quickly high purity 1,4-Butanediol/BDO CAS 110-63-4 1 4 butanediol suppliers australia and US
wickr me:adawang
Whats/Signal/Telegram
+86 18771982534
sales02@whmonad.com
Industrial Use of 1,4-Butanediol:
1,4-Butanediol is used industrially as a solvent and in the manufacture of some types of plastics, elastic fibers and polyurethanes. In organic chemistry. In the presence of phosphoric acid and high temperature, it dehydrates to the important solvent tetrahydrofuran. At about 200 °C in the presence of soluble ruthenium catalysts, the diol undergoes dehydrogenation to form butyrolactone.
Main Poducts
Hot products:
2-Bromo-1-phenyl-1-pentanone CAS 49851-31-2
2-Bromo-4'-Methylpropiophenone CAS 1451-82-7
Methylamine hydrochloride CAS 593-51-1
2-iodo-1-p-tolylpropan-1-one CAS 236117-38-7
Tetramisole hcl CAS 5086-74-8
Diltiazem CAS 42399-41-7
Xylazine/Xylazine hcl CAS 23076-35-9
Pyrrolidine CAS 123-75-1
Phenacetin CAS 62-44-2
Benzocaine CAS 94-09-7
Pregabalin CAS 148553-50-8
4,4-Piperidinediol CAS 40064-34-4
Cannabidiol CAS 13956-29-1
Cialis CAS 171596-29-5
Sildenafil CAS 139755-83-2
Pregabalin CAS 148553-50-8
1-Boc-4-(4-fluorophenylamino)-piperidine cas 288573-56-8
Inquiry me now
Posted by: adawang (verified user)
295 visitors
0 saved

Freelance Content Writer
SEO | Blogs | Technical Writer
Email: himaps94@gmail.com
A new solution for an old problem: ungex protocol
Health & Wellness, Services
Melbourne, Melbourne, Australia